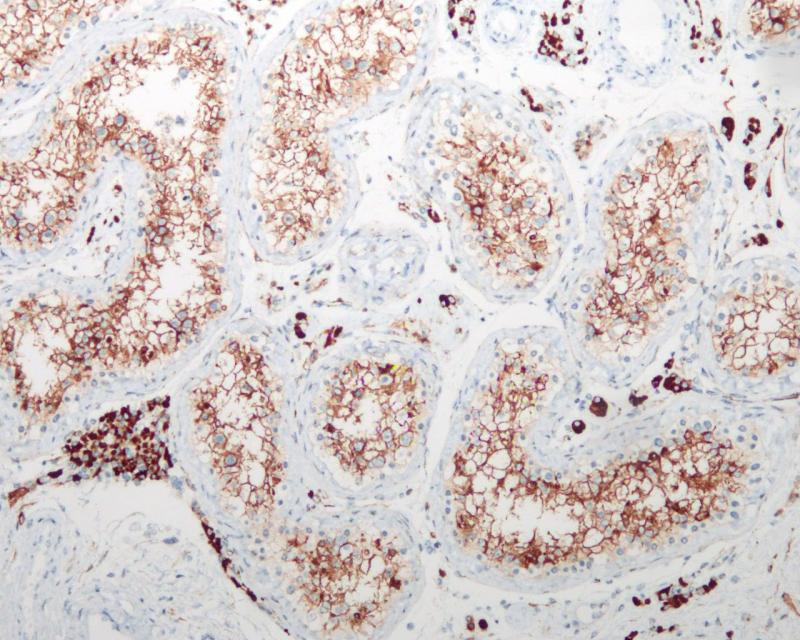
睾丸 ACE2 (BP6153) 染色

产品中心

小肠 ACE2 (BP6153)染色
睾丸 ACE2 (BP6153) 染色
ACE2 重组兔单克隆抗体
ACE2 是一种羧肽酶,能够催化血管紧张素 I 转换成血管紧张素 1-9或者将血管紧张素 II 转换成血管舒张血管紧张素1-7。ACE2 是高血压蛋白原酶-血管紧张素系统 (RAS) 中一个至关重要的组分。ACE2 在心脏和肾脏的血管内皮细胞以及睾丸的 Leydig 和 Sertoli 细胞中表达。ACE2还被发现是SARS和SARS-CoV-2的受体。
Specifications
- 目录号
- BX50175
- 克隆号
- BP6153
- 阳性对照
- 肾
- 亚细胞定位
- 细胞膜
- 组织类型
- FFPE
- 修复方式
- HIER
- 稀释比
- 1:100-1:200
- 规格
- 100μl/vial, 1ml/vial
- 用途
- RUO
Reference
1.Donoghue M, et al. Circ. Res. 87:E1-E9(2000).
2.Hofmann H, et al. Natl. Acad. Sci. U.S.A. 102:7988-7993(2005).


